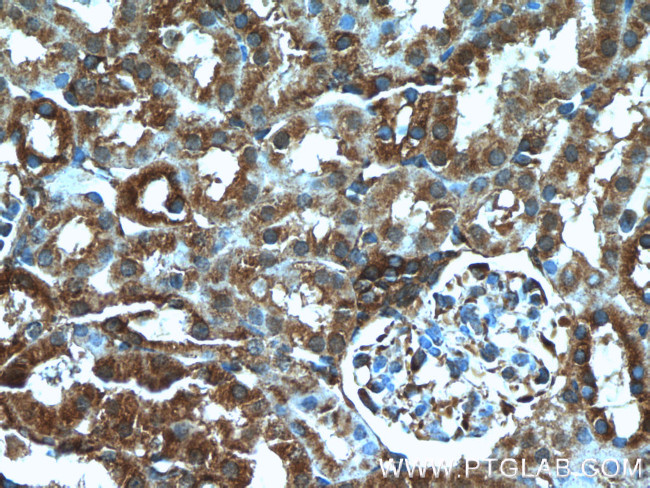
DOCK8 Antibody in Immunohistochemistry (Paraffin) (IHC (P))

Search
Proteintech
DOCK8 Polyclonal Antibody
{{$productOrderCtrl.translations['antibody.pdp.commerceCard.promotion.promotions']}}
{{$productOrderCtrl.translations['antibody.pdp.commerceCard.promotion.viewpromo']}}
{{$productOrderCtrl.translations['antibody.pdp.commerceCard.promotion.promocode']}}: {{promo.promoCode}} {{promo.promoTitle}} {{promo.promoDescription}}. {{$productOrderCtrl.translations['antibody.pdp.commerceCard.promotion.learnmore']}}
产品信息
11622-1-AP
种属反应
已发表种属
宿主/亚型
分类
类型
抗原
偶联物
形式
浓度
规格
纯化类型
保存液
内含物
保存条件
运输条件
产品详细信息
Immunogen sequence: EVYKLVIPI LEAHREFRKL TLTHSKLQRA FDSIVNKDHK RMFGTYFRVG FFGSKFGDLD EQEFVYKEPA ITKLPEISHR LEAFYGQCFG AEFVEVIKDS TPVDKTKLDP NKAYIQITFV EPYFDEYEMK DRVTYFEKNF NLRRFMYTTP FTLEGRPRGE LHEQYRRNTV LTTMHAFPYI KTRISVIQKE EFVLTPIEVA IEDMKKKTLQ LAVAINQEPP DAKMLQMVLQ GSVGATVNQG PLEVAQVFLA EIPADPKLYR HHNKLRLCFK EFIMRCGEAV EKNKRLITAD QREYQQELKK NYNKLKENLR PMIERKIPEL YKPIFRVESQ KRDSFHRSSF RKCETQLSQG S (257-606 aa encoded by BC019102)
靶标信息
The Dedicator of cytokinesis protein 8 (DOCK8) is a member of the DOCK180 family of guanine nucleotide exchange factors. DOCK8 plays an essential role in humoral immune responses and is important in the proper formation of the B cell immunological synapse. Mutations in this gene result in the autosomal recessive form of the hyper-IgE syndrome.
仅用于科研。不用于诊断过程。未经明确授权不得转售。
生物信息学
蛋白别名: 1200017A24Rik; Dedicator of cytokinesis protein 8; epididymis luminal protein 205; unnamed protein product
基因别名: 1200017A24Rik; 5830472H07Rik; A130095G14Rik; AI461977; DOCK8; HEL-205; HIES2; MRD2; ZIR8
UniProt ID: (Human) Q8NF50, (Mouse) Q8C147
Entrez Gene ID: (Human) 81704, (Mouse) 76088